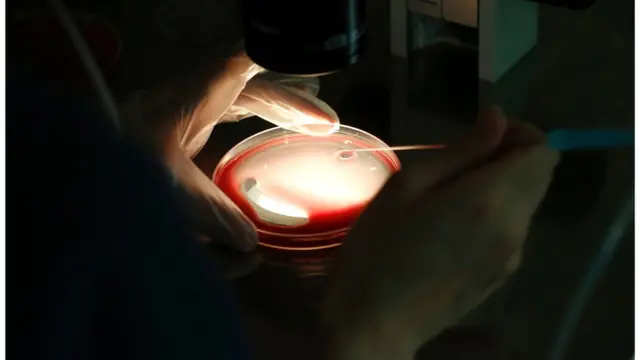
వీర్యకణాల సంఖ్య, అనారోగ్య సమస్యలు

‘వీర్య కణాలు తక్కువగా ఉన్నాయా? ఆరోగ్య సమస్యలు పెరుగుతాయ్’

ఫొటో సోర్స్, Getty Images
- రచయిత, అలెక్స్ థెరియన్
- హోదా, బీబీసీ ప్రతినిధి
వీర్యకణాల సంఖ్య తక్కువగా ఉన్న పురుషులకు ఎక్కువ ఆరోగ్య సమస్యలు ఎదురయ్యే అవకాశం ఉందని ఓ పరిశోధన వెల్లడించింది.
5,177 మంది పురుషులపై పరిశోధన నిర్వహించగా, వీర్యకణాల సంఖ్య తక్కువగా ఉన్నవారిలో - శరీరంలో కొవ్వు, రక్తపోటు, చెడు కొలెస్టరాల్ సమస్యలు ఉత్పన్నమయ్యే అవకాశం 20 శాతం ఎక్కువగా ఉందని గుర్తించారు.
వాళ్లలో టెస్టోస్టిరాన్ (పురుష సెక్స్ హార్మోన్) కూడా తక్కువగా ఉండే అవకాశం ఉంది.
గర్భధారణ విషయంలో ప్రతి మూడు జంటల్లో ఒక జంట వీర్యకణాల సంఖ్య తక్కువగా ఉండడం, వీర్యం నాణ్యత లేకపోవడం అనే సమస్యలు ఎదుర్కొంటోంది.
వీర్యకణాల సంఖ్య కూడా పురుషుల ఆరోగ్యంపై ప్రభావం చూపుతుందా అని పరిశోధిస్తూ సైంటిస్టులు ఇటలీలో పిల్లలు లేని దంపతులను పరిశీలించారు.
వారి పరిశోధనలో వీర్యకణాల సంఖ్య తక్కువ ఉన్న పురుషుల్లో బాడీ మాస్ ఇండెక్స్ (బీఎమ్ఐ) ఎక్కువగా ఉన్నట్లు, వారి రక్తపోటు పెరిగినట్లు గుర్తించారు.

ఫొటో సోర్స్, Science Photo Library
వీర్యకణాల సంఖ్య తక్కువగా ఉన్న పురుషుల్లో టెస్టోస్టిరాన్ స్థాయి తక్కువగా ఉండేందుకు 12 రెట్లు ఎక్కువ అవకాశం ఉంది. దీని వల్ల కండరాల బరువు, ఎముకల సాంద్రత తగ్గి, ఎముకలు సులభంగా విరిగేందుకు ఆస్కారం ఏర్పడుతుంది.
ఈ పరిశోధనకు నేతృత్వం వహించిన డాక్టర్ అల్బర్టో ఫెర్లిన్- ''వంధ్యత్వం ఉన్న పురుషులు అనేక ఆరోగ్య సమస్యలు ఎదుర్కొనే అవకాశం ఉంది. పురుషుల వీర్యాన్ని పరిశీలిస్తే దాని వల్ల వారి ఆరోగ్యాన్ని అంచనా వేసి, రోగాలను అరికట్టవచ్చు'' అని తెలిపారు.
''గర్భధారణ విషయంలో సమస్యలు ఎదుర్కొంటున్న దంపతుల్లో పురుషులకు సంతాన సాఫల్య నిపుణులు సరిగ్గా వైద్య పరీక్షలు చేయాలి. ఎందుకంటే వారిలో వ్యాధిగ్రస్తత, మరణించే అవకాశాలు ఎక్కువ'' అని ఆయన వివరించారు.
ఫొటో సోర్స్, Getty Images
ఈ పరిశోధన నిర్వహించిన సైంటిస్టులు - వీర్యకణాల సంఖ్య తక్కువగా ఉండడమే జీవక్రియ సమస్యలకు కారణమని నిరూపణ కాలేదని, అయితే రెండింటి మధ్యా సంబంధం ఉన్నట్లు తెలుస్తోందని వివరించారు.
అందువల్ల సంతాన సాఫల్య కేంద్రాలు కేవలం వీర్యకణాల సంఖ్యపైనే కాకుండా వారి ఆరోగ్య సమస్యలపైనా దృష్టి పెట్టాల్సిన అవసరముంది.
ఈ అంశంపై యూనివర్సిటీ ఆఫ్ షెఫీల్డ్లో ఆండ్రాలజీ ప్రొఫెసర్ అల్లెన్ పేసీ మాట్లాడుతూ- పురుషుల్లో వంధ్యత్వ సమస్యలు, ఇతర ఆరోగ్య సమస్యల మధ్య సంబంధాన్ని తెలుసుకొనేందుకు మరిన్ని పరిశోధనలు జరగాల్సి ఉందని తెలిపారు.
''కేవలం వంధ్యత్వమే ఆరోగ్య సమస్యలకు కారణమని చెప్పడానికి ప్రస్తుతం బలమైన రుజువులేమీ లేవు. అయితే ఆ రెండింటి మధ్యా సంబంధం ఉండవచ్చు. పురుషుల్లో ఆరోగ్య సమస్యలను ముందస్తుగా గుర్తించేందుకు వంధ్యత్వంపై మరిన్ని పరిశోధనలు జరగాలి'' అని ప్రొఫెసర్ అల్లెన్ అన్నారు.

ఫొటో సోర్స్, Getty Images
ఇవి కూడా చదవండి:
- థాయ్లాండ్లో పురుషాంగాన్ని తెల్లగా మార్చే చికిత్స
- #HerChoice: నపుంసకుడని చెప్పకుండా నాకు పెళ్లి చేశారు!
- ఆమె అతడై.. అతడు ఆమెయై.. తర్వాత ఒక్కటై
- స్మార్ట్ఫోన్తో ఆడుకునే మీ పిల్లలు పెన్సిల్ను సరిగ్గా పట్టుకోగలరా?
- వీడియో గేమ్ కొట్లాట.. 13 ఏళ్ల అక్కను కాల్చి చంపిన 9 ఏళ్ల బాలుడు
- ‘గ్యాస్’ ప్రాబ్లమ్? ఎందుకిలా వదులుతారు? దీన్ని ఆపొచ్చా?
(బీబీసీ తెలుగును ఫేస్బుక్, ఇన్స్టాగ్రామ్, ట్విటర్లో ఫాలో అవ్వండి. యూట్యూబ్లో సబ్స్క్రైబ్ చేయండి.)








